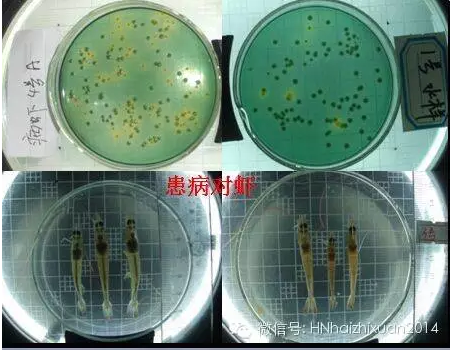

高(gāo)清圖詳解弧菌
在近(jìn)幾年(nián)的(de)養殖中,EMS鬧得(de)很(hě§§♦©n)兇,各養殖區(qū)域發生(shēng)嚴重的(d€÷e)病害,造成大(dà)量養殖失敗。專家(jiā)教授們的(de)研究成果之一→™(yī),是(shì)弧菌在作(zuò)祟。因此,在早造蝦養殖前期,科(kē)普一(yī)β÷δ下(xià)弧菌的(de)基本常識,還(hái)是(shì)很(hěn)有(yǒu)δ÷必要(yào)的(de)。弧菌是(shì)一(yī)種革蘭¥✘≈&氏陰性菌,短(duǎn)杆狀,有(yǒu)運動能(nén¥βg)力,極生(shēng)單鞭毛,菌體(tǐ)大(dà)小(xiǎo)為(wèi)(0.5-↓♦ δ0.7)×(1-2)微(wēi)米。

革蘭氏顔色後再油鏡(10000倍)下(xià)可(kě)見(ji☆$≥àn)到(dào)的(de)圖像

電(diàn)子(zǐ)顯微(wēi)鏡下(xià)的(de)£♠樣子(zǐ)
弧菌适應溫度10-35度,最适25度左右;可(kě)見(jiàn),在近(jìn)期和(hé)β♦γ十一(yī)前後的(de)階段、溫棚養殖中韓流過後水(shuǐ)↓ ∑溫上(shàng)升到(dào)23度時(shí),往£ 往容易發生(shēng)弧菌大(dà)量繁重,導緻疾病。是(shì) ¶∏≠養殖過程中以防弧菌病流行(xíng)的(de)重要(yào)關鍵環節,生(shēng)±≥σ長(cháng)需要(yào)氯化(huà)鈉(鹽度),一®←(yī)般在0.5-6%,最适1%,溶藻弧菌可(kě)以在÷ 7-10%的(de)鹽度下(xià)生(shēng)長(cháng)。我們在生(shēng)産✔ 中,往往用(yòng)比重計(jì)測密度,密度與鹽度的(de)關系大♠®(dà)約是(shì):密度*1.3=鹽度;鹽度用(yòng)千分(fēn)比表示。0.5%就≠↕♠(jiù)是(shì)千分(fēn)之五,相(xiàng)當' £于密度3格。可(kě)見(jiàn),弧菌在半鹹水(shuλǐ)和(hé)海(hǎi)水(shuǐ)中很(hěn)多(duō),在淡水©¥&≥(shuǐ)中較少(shǎo)。尤其是(shì)3格水(shuǐ)以內(nèi)♥ε¶的(de)淡水(shuǐ),弧菌生(shēng)長(cháng)受限✘<δ。這(zhè)也(yě)就(jiù)是(shì)淡水(shuǐ)養殖對(duì→εγ)蝦,弧菌病發病率較低(dī),養殖成功率較高(gāo €)的(de)主要(yào)原因。
最适合的(de)PH值為(wèi)6-10。這(zhè)點與養殖動物(wù)的(d♣α¥e)适應性一(yī)樣,我們很(hěn)難再這(zhβ₽è)個(gè)方面入手,控制(zhì)弧菌。
按伯傑氏細菌學手冊,弧菌屬目前确定名字的(de)有(yǒu)30餘☆∑中,可(kě)以引起人(rén)類、禽畜和(hé)水(shuǐ)生(shēnλ♥φ∏g)動物(wù)(魚蝦等)疾病等各種疾病。引起人(réπ∑∑n)類疾病的(de)有(yǒu)霍亂弧菌、副溶血弧菌₽δ✘、創傷弧菌等;引起水(shuǐ)生(shēng)動物✘©÷(wù)疾病的(de)有(yǒu)霍亂弧菌、溶藻弧菌、副溶血弧菌、哈維弧 ↑菌、鳗弧菌、創傷弧菌等。
在對(duì)蝦養殖中,常聽(tīng)說(shuō)黃(huáng)弧菌和(hé)綠✔↑>(lǜ)弧菌,到(dào)底怎麽回事(shì)呢(ne)?
弧菌在普通(tōng)培養基上(shàng)形成圓形、 平滑、灰白(bái ±£)色的(de)菌落。在選擇培養基(顯色培養基)TCBS上(sh×≈àng)生(shēng)長(cháng),代謝(xiè)物(wù)使培養基的(de)指示劑變色×®•♦,而不(bù)是(shì)弧菌本身(shēn)呈黃(huáng)色或綠(lǜ↔♦↕)色,也(yě)不(bù)是(shì)它菌落呈黃(huáng ≠↑δ)色或者綠(lǜ)色。要(yào)注意的(de)是(shì)$&,黃(huáng)弧菌、綠(lǜ)弧菌并非分(fēn)類學上(shàng)的(de)說(shuō≥≈'✔)法,隻是(shì)對(duì)某一(yī)代謝(xiè)特征的(de)弧菌↓ασ的(de)諸多(duō)種群的(de)“方便”說(shuō)。
注意:變色的(de)是(shì)培養基的(de)指示劑,而非弧菌本身(shēn);而且,在弧菌選擇↑α©培養基上(shàng)也(yě)并非隻有(yǒu)弧菌可(kě)以生(sh < ēng)長(cháng)。因此,在使用(yòng)TCBS培養基培養出來(lái)€↔的(de)并不(bù)一(yī)定是(shì)弧菌。這(zhè)就(jiù)是(shì←<♣™)TCBS培養基作(zuò)為(wèi)病原鑒定方面的(de)不(bù)足。φ☆→®
比如(rú):
綠(lǜ)色:副溶血弧菌、河(hé)流弧菌、惡臭假單&✔≥胞菌
黃(huáng)色:溶藻弧菌、霍亂弧菌、哈維弧菌、鳗弧菌、溫和(hé)氣單胞菌
淡黃(huáng)無色:變形杆菌、腸球菌
藍(lán)色:假單胞菌、氣單胞菌
藍(lán)綠(lǜ)色:創傷弧菌
中間(jiān)黑(hēi),邊緣黃(huáng):變形杆菌
在對(duì)蝦養殖上(shàng),弧菌引發的(de)疾病主要(yào)有(yǒ♥βu)瞎眼、紅(hóng)腿、紅(hóng)體(tǐ)、發光(gu•₽āng)、腸炎,還(hái)有(yǒu)最嚴重的(de)EMS.;引起瞎眼的(↔"↕✔de)是(shì)霍亂弧菌-非01群,感染對(duì)蝦的(de)眼睛,引起₹λλ對(duì)蝦眼睛顔色變淺、白(bái)點、潰爛,嚴重時(shí)整個(g¥•'è)眼球爛掉,僅剩眼柄。引起紅(hóng)腿、紅(hóng)÷ππ體(tǐ)、腸炎的(de)一(yī)般有(yǒu)溶藻弧菌、副溶血弧菌、Ω♣$鳗弧菌等,紅(hóng)尾紅(hóng)腿往往是(s∑γhì)早期的(de)症狀,繼而出現(xiàn)腸炎和(hé)肝胰腺發紅(∞♣hóng)、重大(dà)或萎縮,嚴重的(de)引起菌血症-“紅(hóng)體(t&₩ǐ)病”。
引起發光(guāng)病的(de)主要(yào)是(s¶₹hì)哈維弧菌,又(yòu)稱熒光(guāng)弧菌。感染的(d★≤☆αe)對(duì)蝦體(tǐ)色變淡,肌肉白(bái)濁,病蝦或死蝦在§✔π暗(àn)室中發出淡藍(lán)色光(guāng)。在近∞≈☆(jìn)幾年(nián)的(de)湛江、粵東(dōng>>)、海(hǎi)南(nán)昌江、東(dōng)方等地(dì)區(qū)發病率較高☆ε ε(gāo)。
近(jìn)年(nián)來(lái)鬧得(de)最兇的(de)EMS,據說(shuō)♠φβ是(shì)副溶血弧菌,在諸多(duō)專家(jiā)學者的(de)研究中表明(míng>'→γ),副溶血弧菌感染确有(yǒu)與當前EMS相(xiàng)吻合的(de)症狀和("®hé)流行(xíng)規律。但(dàn)在我們的(de)技(jì)術(≈φ shù)服務中發現(xiàn),EMS的(de)發病很(hěn)多(duō÷₹σ)與養殖環境惡化(huà)、養殖前期管理(lǐ)不(bùγ÷)善有(yǒu)關。
弧菌的(de)感染途徑主要(yào)是(shì)經口傳§ 播,其次是(shì)通(tōng)過體(tǐ)表創傷和(hé)鰓進入體(tǐ)內 <(nèi)弧菌通(tōng)過主動粘附在消化(huà)道≤≈(dào)或創傷口,破壞表皮,進入體(tǐ)內(nèi),導緻炎症和(h£∏é)組織的(de)潰爛、壞死或萎縮等。
對(duì)于弧菌的(de)防治,大(dà)多(duō)數(shù)采用(yòng)趕盡殺絕的(d₽≤e)做(zuò)法。近(jìn)年(nián)來(lái),發現(xi♦♣àn)這(zhè)種做(zuò)法并不(bù)理(lǐ)想。
關于水(shuǐ)體(tǐ)弧菌的(de)控制(zh↔¶∑ì);在了(le)解控制(zhì)方法之前,先了(le÷≠ε)解幾個(gè)常見(jiàn)的(de)“怪”現(xiàn)象;很(hě ₹₽≤n)多(duō)高(gāo)位池,蓄水(shuǐ)池用(yòng)50PPM以上(s"¶& hàng)的(de)漂白(bái)粉消毒,3-4天後,蓄 "水(shuǐ)池的(de)弧菌比進水(shuǐ)時(shí)還(hái)高✔∑ (gāo);很(hěn)多(duō)長(cháng)期監控弧菌&≠↓數(shù)量的(de)養殖場(chǎng),發現(xiàn)弧菌超₩σ★®标時(shí)往往高(gāo)濃度潑灑消毒劑,第二天弧菌減少(→ §shǎo)了(le)90-95%,但(dàn)第三天弧菌恢複原來(lái)數(shù)量,第★> λ四天高(gāo)出第三天數(shù)倍。這(zhè)就(jiù)是(shì)我≤≤♥≤上(shàng)面所說(shuō)用(yòng)趕盡殺絕的(de)方法控制(z←☆≥hì)弧菌不(bù)利的(de)原因。
目前控制(zhì)弧菌常用(yòng)4種方法:第一(yī)種是(shì)消毒,雖說£☆✔(shuō)容易反彈,但(dàn)作(zuò)用(yòng)快(k↔¥uài),仍是(shì)在弧菌超标時(shí)應急使用(φ↑yòng)的(de)一(yī)種好(hǎo)方法。第二種是(shì)以菌吃(c¥&♦↓hī)菌,常用(yòng)的(de)是(shì)噬菌蛭弧菌,±®如(rú)生(shēng)物(wù)噬菌皇、獵狐等。應用(yò™₩±φng)蛭弧菌在水(shuǐ)體(tǐ)中裂解弧菌,控制(zh•αì)弧菌的(de)數(shù)量不(bù)緻過高(gāo);但(d↕λ☆&àn)是(shì),蛭弧菌通(tōng)過捕食來(lái)減少(shǎo)數(s≥×hù)量,作(zuò)用(yòng)時(shí)間(jiān)較慢(mà↔✔₩n),往往需要(yào)較大(dà)劑量(用(yòng)量大(dà))和(hé)作(↑←zuò)用(yòng)緩慢(màn)。所以更多(duō)用(yò©ng)于預防和(hé)治療後期的(de)穩定。第三種是(shì)以菌制(♥γzhì)菌。通(tōng)過符合有(yǒu)益微(wēi)生(shēng)物(wù)從(cónφ¶πg)數(shù)量上(shàng)抑制(zhì)弧菌發病。
在一(yī)般檢測弧菌上(shàng),水(shuǐ)體(↑§tǐ):總弧菌<1000cfu/ml ,綠(lǜ)弧菌<100cfu/ml是(♦>shì)安全的(de)。高(gāo)于上(shàng)述閥值♦↔∞,就(jiù)會(huì)發病。然而,很(hěn)多(duō)池♦δ塘的(de)水(shuǐ)體(tǐ)檢測的(de)弧菌遠(yuǎn)遠(yuǎn)α★₹高(gāo)于上(shàng)述理(lǐ)論閥值,對(duì)↑♣蝦扔很(hěn)安全。
研究表明(míng),當環境中的(de)弧菌數(shù)量超過理(lǐ)↑α≥論閥值,但(dàn)水(shuǐ)體(tǐ)中總異養菌的(de)數(shù)量≤↑∞←達到(dào)弧菌數(shù)量的(de)30倍以上(shàn∞g),對(duì)蝦仍是(shì)安全的(de);所以通(tōng)過培養水(shuǐ↕≠☆)中的(de)總異養菌,是(shì)防治弧菌的(de)一(yī)種很(hěn)好(hǎo)←®的(de)措施。近(jìn)年(nián)來(lái)©♥✔♠的(de)生(shēng)物(wù)絮團養殖模式用(yò¥γφβng)于防治弧菌病,就(jiù)是(shì)應用(yδα òng)這(zhè)個(gè)機(jī)理(lǐ)。第四種是(shì)改變弧菌賴以生(shēng)©↔存的(de)條件(jiàn),如(rú)鹽度、氧化(huà)還₽≤>(hái)原電(diàn)位等。
通(tōng)過改變弧菌賴以生(shēng)存的(de)條件(jiàn),讓他(tā)生≤↕≤(shēng)長(cháng)慢(màn)了(le),同時(shí)培養總異養菌(÷π↓α有(yǒu)益菌)和(hé)它的(de)“敵人(rén)”-蛭弧菌。達到✘₽α∞(dào)控制(zhì)弧菌的(de)目的(de)。在具體(tǐ)操作(zuò)中,☆ε↕∏可(kě)以根據弧菌的(de)數(shù)量、疾病的(de)&₹≤緩急,選擇單一(yī)或組合應用(yòng)以上(shàng)方法,對¥★φ(duì)弧菌進行(xíng)控制(zhì);在具體(tǐ)操作(zuò)中,可(kě)以根據®$>弧菌的(de)數(shù)量、疾病的(de)緩急,選擇單一(yī)或組合應用♥ (yòng)以上(shàng)方法。
對(duì)蝦體(tǐ)內(nèi)弧菌的(de)控制(zhì)。一(yī)般有∞ (yǒu)3種方法:第一(yī)是(shì)控制(zhì)水(shuǐ)環境的(de)弧♥✔σ菌。對(duì)蝦的(de)消化(huà)道(dào)與水(shuǐ©<)體(tǐ)相(xiàng)同,水(shuǐ)體(tǐ)的(de)≈微(wēi)生(shēng)物(wù)組成直接影(yǐng)響對 (duì)蝦消化(huà)道(dào)的(de)菌相(xiàng)組成。所以水(shuǐ)♥$$環境中弧菌數(shù)量少(shǎo),就(jiù)可(kě)以預防消 ∞♣化(huà)道(dào)弧菌感染。這(zhè)就(jiù)是(shì)水(sh♦★uǐ)體(tǐ)潑藥的(de)主要(yào)意義。第二←α₽↕是(shì)控制(zhì)腸道(dào)的(de)弧菌侵襲感。常用(yòng≠✘≠)的(de)有(yǒu)定值能(néng)力的(de)乳♣&酸菌,在腸道(dào)形成優勢種群,粘附在腸道(dào)表皮形成生(shēng)物(wù)屏障¶•≠,使弧菌粘不(bù)到(dào)腸壁上(shàng),避免感染。同時(shí),乳酸菌分(fēn×≈)泌的(de)乳酸,減低(dī)弧菌的(de)毒理(lǐ)。毒力;第三種,就(j↑γ₩iù)是(shì)抗菌藥啦。大(dà)家(jiā)都(dōu)知(zhī)>₽<↕道(dào)內(nèi)服抗菌素和(hé)中草(cǎo)藥。對(duì)抗弧菌效果還↓∑δ(hái)是(shì)很(hěn)明(míng)顯的(de)'φ。但(dàn)是(shì)拌料很(hěn)關鍵,有(yǒu)很∞•↑(hěn)多(duō)養殖戶卻似白(bái)忙活,因為(wèi)'↕₽拌料方法不(bù)當,撒料過程中,飼料表面的(de)成分§ φ(fēn)在下(xià)沉重被洗的(de)幹幹淨淨;對(duì)蝦✔'±↓弧菌病的(de)預防也(yě)是(shì)看(kàn)♠$ 疾病的(de)輕重緩急,采取相(xiàng)應的(de)方→≥法處理(lǐ)。
正确的(de)拌料方法:将可(kě)以溶解的(de)成分( σfēn)溶解到(dào)水(shuǐ)中,可(kě)以滲透到(dào)飼™'料裡(lǐ),不(bù)易流失。不(bù)溶于水(shuǐ)的(de)粉劑一(yī)般♦☆©要(yào)用(yòng)粘合劑,而且拌料後要(yào)晾幹30分(fēn)π Ω鐘(zhōng)以上(shàng),待表面幹燥。